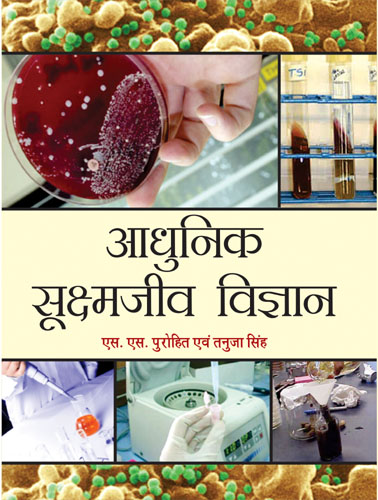

Ebook
ISBN: 9789391568634
Chapter: Practical Microbiology
Chapter No.: 43Contributors:
List of All Chapters
1 - Microbiology : Introduction And His...
2 - Origin, Evolution And Biodiversit...
3 - Taxonomy Of Microorganisms...
4 - Nature, Classification, Morphology ...
5 - Bacteriophages...
6 - Viruses Of Eucaryotes...
7 - Mycoplasmas And Mycoplasmas Viruses...
8 - Mycobacteria, Myxobacteria, Ricke...
9 - Bacteria: Classification, Nomencl...
10 - Bacteria : Eubacteria...
11 - The Bacteria: Archaeobacteria, Ac...
12 - Cyanobacteria...
13 - Eucaryota: Algae ...
14 - Eucaryota: Fungi...
15 - Protozoa...
16 - Biology Of Lichens...
17 - Growth And Differentiation, Nutriti...
18 - Genetics Of Microorganisms...
19 - Genetic Engineering And Protein E...
20 - Mutations In Microorganisms...
21 - Methods Of Sterilization And Disi...
22 - Environmental Microbiology...
23 - Soil Microbiology: Geochemical Cycl...
24 - Microbiology Of Air...
25 - Microbiology Of Water...
26 - Microbiology Of Foods...
27 - Microbiology Of Dairy And Dairy P...
28 - Microorganisms And Diseases In Ma...
29 - Human Pathogenic Viruses...
30 - Human Pathogenic Bacteria...
31 - Human Pathogenic Protozoa...
32 - Microorganisms And Plant Diseases...
33 - Plant Pathogenic Viruses...
34 - Plant Diseases Caused By Bacteria...
35 - Plant Pathogenic Fungi...
36 - Antimicrobial Drugs And Sensitivi...
37 - Microbes In Economic Use...
38 - Industrial Enzymes, Fermentation ...
39 - Microbial Biopesticides, Biofungici...
40 - Microbial Biological Fertilizers...
41 - Microscopy...
42 - Preparation And Inoculation Of Cu...
43 - Practical Microbiology...
Book Details
Book Title:
A Textbook Of Microbiology
A Textbook Of Microbiology
Book Type:
TEXTBOOK
TEXTBOOK
No Of Pages:
596
596
Color Pages :
0
0
Color Pages :
0
0
Book Size:
AMERICAN ROYAL (6X9)
AMERICAN ROYAL (6X9)
Weight:
600 Gms
600 Gms
Copyright Holder:
All Rights Reserved
All Rights Reserved
Imprint:
STUDENT EDITION
STUDENT EDITION
Readership:
PG STUDENTS | UG STUDENTS |
PG STUDENTS | UG STUDENTS |
Associated Subjects:
Agricultural Sciences , Life Sciences , Veterinary And Animal Sciences , Pharmacy , Environmental Sciences ,
Agricultural Sciences , Life Sciences , Veterinary And Animal Sciences , Pharmacy , Environmental Sciences ,